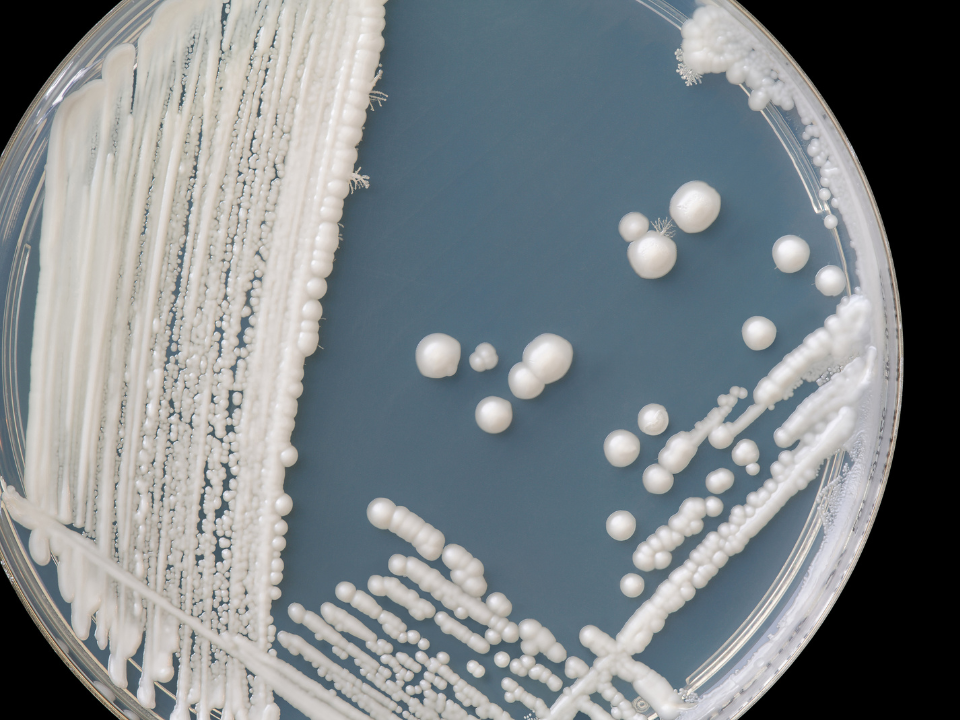
candida albicans como causadora de infecções do trato urinário itu

Infecções do trato urinário (ITU) podem ser causadas por diversas espécies de microrganismos, mas em sua maioria, causadas por bactérias. Contudo, na atualidade há um aumento de casos de infecções de etiologia fúngica, quase que invariavelmente por espécies de Candida, causando candidúria. Dados sobre a prevalência de culturas de urina obtidas de pacientes hospitalizados em toda a Europa descobriram que as espécies de Candida foram o terceiro microrganismo mais isolado.
Leveduras desse gênero fazem parte da microbiota normal do trato urinário, no entanto pode se tornar patógena. Os fatores predisponentes para tais infecções estão em grande parte associados a fatores do hospedeiro incluindo: imunossupressão, uso de antibioticoterapia de amplo espectro, período prolongado de internação em unidade de terapia intensiva, uso de cateteres, ventilação mecânica, nutrição parenteral, quimioterapia, anormalidades do trato urinário e diabetes (Voltan A.R, et al., 2014; Silva A.K et al., 2014).
As leveduras são patógenos oportunistas e expõe riscos a pacientes graves e debilitados. Pesquisas indicam que a evolução da candidúria para candidemia pode ocorrer, contudo o diagnóstico precoce diminui as chances. Um estudo com mais de 500 pacientes com candidúria mostrou que apenas 1,3% dos pacientes desenvolveram candidemia. Ainda assim, estudos mostram que pacientes em UTI com candidúria têm taxa de mortalidade maior comparado a pacientes com as mesmas características sem candidúria. (Naves P.L.F et al., 2013).
A ITU é diagnosticada por meio de análise da urina e cultura quantitativa. A coleta de urina em estágio inicial, antes das reações inflamatórias ou mesma quando se faz uso de antissépticos pode dar resultados falsos sobre a contaminação e para tanto, a realização do exame exige higiene adequada e desprezo do jato inicial de urina, coletando o jato médio (Dias A. A et al., 2018).
Ao exame direto serão visualizadas leveduras em solução fisiológica ao microscópio óptico. Concomitante, para a cultura de urina, o meio de cultivo especifico para fungos é o ágar Sabouraud Dextrose (ASD), entretanto apresenta bom crescimento em ágar cled ou ágar sangue. A espécie mais isolada de ITU é C. albicans, mas as espécies não albicans tem sido frequente como a C. tropicalis, C. glabrata, C. krusei e C. parapsilosis, inclusive exibindo perfil de resistência aos antifúngicos utilizados no tratamento de candidúria (Moreira L.S et al., 2017).
Na cultura de urina, considera-se crescimento significativo, contagens superiores que 100.000 colônias/mL. A candidíase do trato urinário inferior é geralmente o resultado de uma infecção retrógrada, enquanto a infecção parenquimatosa renal geralmente segue candidemia. Além da candidúria assintomática, as formas clínicas reconhecidas de ITU por Candida incluem infecção da bexiga e infecção parenquimatosa renal (Moreira L.S et al., 2017).
Como medidas de Biossegurança para evitar infecções urinárias recorrentes pelo gênero Candida, destacamos:
1) Lavagem da região do períneo antes da relação sexual;
2) Aumento da ingestão hídrica: a ingestão de líquido mantém a urina mais diluída e faz com que o paciente sinta necessidade de urinar com mais frequência, ajudando a expelir leveduras que estejam no trato urinário. Um recente estudo randomizado com 140 mulheres com histórico de pelo menos três episódios cistite por ano e baixo consumo de líquidos (menos de 1,5 litro por dia) mostrou que beber 2 a 3 litros de água por dia ajuda a reduzir em 50% o número de casos novos de cistite;
3) Uso de roupas de algodão ou tecidos leves: Roupas leves diminui a umidade da região genital. A pele úmida e abafada por muito tempo, não permitem a circulação do ar e favorece a proliferação de fungos;
4) Evite o uso indiscriminado de antibióticos e utilize apenas com prescrição médica: O uso indiscriminado de antibióticos pode alterar a composição da microbiota vaginal, eliminando as bactérias e os fungos por sua vez, podem aumentar sua população e causar candidíase, ou infecção urinária;
5) Evite ducha vaginal: Duchas vaginais não ajudam na higiene íntima e ainda facilitam a migração de fungos para o trato urogenital;
6) Controle o consumo de glicose: pacientes diabéticos ou que cursam com crises de hiperglicemia são mais vulneráveis a infecções de etiologia fúngica, uma vez que os fungos necessitam da glicose para metabolizar e reproduzir.
Nesse contexto, a incidência da infecção do trato urinário por Candida vêm aumentando nos últimos anos, entretanto mais estudos são necessários para esclarecer a patogênese de espécies emergentes, elucidando todo o processo de adesão ao epitélio do trato geniturinário. Medidas de prevenção são imprescindíveis, uma vez que se trata de fungos de caráter oportunistas, sendo a maioria dos casos com manifestações clínicas leves e prognóstico favorável. Entretanto, em pacientes imunodeprimidos, pode ocorrer a progressão da doença para cistite, pielonefrite ou até para candidíase renal, podendo agravar o quadro clinico desses pacientes.
Silva AKF, Lisboa JES, Barbosa MPCS, Lima AF. Infecções urinarias nosocomiais causada por Fungo Do Gênero Candida: Uma Revisão. Caderno de Graduação-Ciências Biológicas e da Saúde-UNIT-Alagoas, 2014;2(1), 45-57
Voltan AR, Fusco-Almeida AM, Mendes–Giannini MJS. Candiduria: epidemiology, resistance, classical and alternative antifungals drugs. SOJ Microbiol Infect Dis, 2014;2(2):1-7.
Naves PLF, Santana DP, Ribeiro EL, Menezes ACS. Novas abordagens sobre os fatores de virulência de Candida albicans. Revista de Ciências Médicas e Biológicas, 2013;12(2):229-233.
Moreira LS, Doria ACOC, Santos TB, Figueira FR, Sorge CDPC, Silva AM, Khouri S. Estudo da resistência aos antifúngicos de leveduras isoladas de candidúrias de um hospital de médio porte. Revista Univap, 2017;23(43):44-52.
Dias AA, Toledo FJL, Vasconcellos FR, Zanatta AP, Menezes T. Aspectos importantes sobre candidúrias: prevalência, agentes etiológicos, diagnóstico e tratamento. Revista Uningá Review, 2018;23(2).

Jorge Luiz Silva Araújo-Filho (@dr.biossegurança): Biólogo, mestre em patologia, doutor em biotecnologia; palestrante e consultor em biossegurança.
Contato: jorgearaujofilho@gmail.com

Gleiciere Maia Silva (@profa.gleicieremaia ): Biomédica, Especialista em Micologia, Mestre em Biologia de Fungos e Doutoranda em Medicina Tropical.